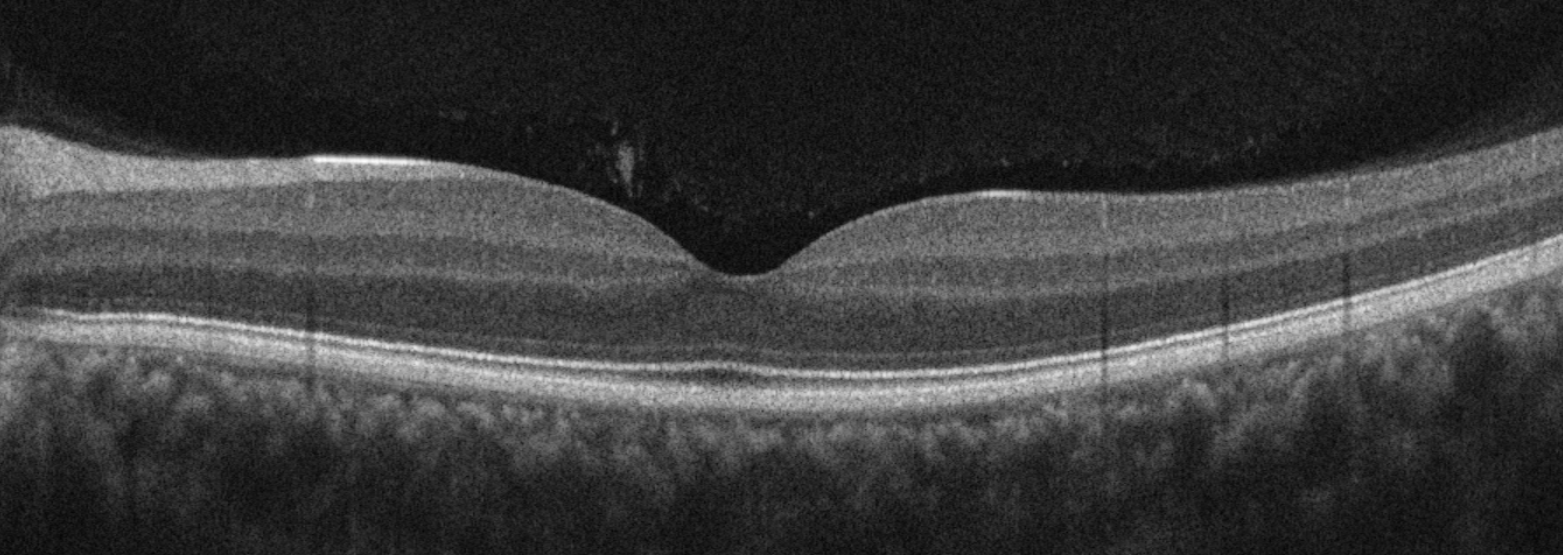

What Are Floaters—and When Should You Worry?
Have you ever looked up at a clear blue sky or a blank white wall and noticed small specks, threads, or cobweb-like shapes drifting across your vision?
These are called floaters. While they may appear to be floating in front of your eye, they are actually tiny structures inside the eye itself, casting shadows onto the retina—the light-sensitive layer at the back of the eye.
For most people, floaters are harmless. But in some cases, they can be an important warning sign.
Quick summary
Floaters are very common and usually harmless
Often caused by natural ageing of the vitreous gel
Sudden onset floaters or flashes should be checked urgently
Most cases do not require treatment
What causes floaters?
The inside of the eye is filled with a clear gel called the vitreous. It is made up of:
99% water
collagen fibrils
hyaluronic acid
As we age, this gel naturally changes.
- The gel begins to liquefy (a process called syneresis)
- The collagen fibres can clump together
- These clumps cast shadows that we see as floaters
This is a normal part of ageing—but it can be more noticeable in some people.
Vitreous syneresis: Age-related changes in the vitreous gel can lead to collagen clumping, which appears as floaters.
Who is more likely to develop floaters?
Floaters can occur in anyone, but are more common if you:
Are short-sighted (myopic)
Have had cataract surgery
Have had eye inflammation or trauma
Are getting older
In fact, many patients notice floaters more prominently after cataract surgery as the visual clarity improves.
Types of floaters
Floaters can appear in different forms:
Thread-like strands
Common in younger or myopic patientsSmall dots
Caused by collagen aggregation in the vitreous. Less commonly, they may be due to inflammation inside the eye (such as uveitis).Cloud-like clumps
Usually caused by collagen changes within the vitreous gel. Occasionally, they may be due to small amounts of bleeding into the vitreous (for example, in more advanced retinal conditions such as diabetic retinopathy).Weiss ring
A circular floater seen after a posterior vitreous detachment (PVD)
⚠️ A Weiss ring is often more noticeable and can appear suddenly. Two examples of Weiss rings are shown below:
A Weiss ring: a circular floater seen after a posterior vitreous detachment.
What is a Posterior Vitreous Detachment (PVD)?
As the vitreous gel continues to liquefy, it can eventually separate from the retina. This is called a posterior vitreous detachment (PVD), and it is:
very common
usually harmless
often associated with a sudden increase in floaters
However, in some cases, the vitreous can pull on the retina during this process, which may cause tears in the retina or even a retinal detachment.
When should you worry?
While most floaters are benign, you should seek urgent assessment if you notice:
A sudden shower of floaters
Flashes of light (especially in the dark)
A shadow or curtain in your vision
Sudden worsening of vision
These symptoms may indicate:
a retinal tear
or a retinal detachment
Around 10–15% of patients with an acute PVD may develop a retinal tear.
The good news is that if detected early, retinal tears can often be treated with laser in the clinic, preventing more serious complications. If you’re unsure whether your symptoms are normal, a retinal examination can quickly determine whether everything is safe.
Do floaters affect vision quality? (Often overlooked)
Floaters are not always just a minor nuisance. Research has shown that in some patients, vitreous opacities can:
scatter incoming light
reduce contrast sensitivity
affect reading, driving, and screen use
In more significant cases, this is referred to as vision degrading myodesopsia (VDM). This explains why some patients feel their vision is “not quite right,” even if standard vision tests are normal.
In some cases, specialised imaging can help visualise vitreous changes associated with floaters. This is not always necessary, but can be useful in selected cases.
OCT imaging: demonstrating vitreous opacities within the premacular bursa, a recognised source of symptomatic floaters.
Do floaters go away?
In many cases:
The brain gradually learns to ignore them
They become less noticeable over time
However:
They may not completely disappear
Some patients continue to find them bothersome
What can be done for floaters?
Most cases:
No treatment is required
Reassurance and monitoring are sufficient
If floaters are severe and affecting quality of life:
In selected cases, treatment may be considered:
Vitrectomy (floaterectomy)
Surgical removal of the vitreous gel
Can be highly effective
But carries risks (e.g. cataract, retinal detachment)
Studies suggest that vitrectomy can significantly improve symptoms in carefully selected patients, although it is generally reserved for more severe cases.
Laser vitreolysis (YAG laser)
Attempts to break up floaters
Results can be variable
Not suitable for all types of floaters
➡️ The key is careful patient selection and discussion of risks vs benefits.
For patients with milder but still bothersome floaters, a non-invasive approach may be appropriate. In selected cases, I may recommend a targeted nutritional supplement (such as formulations containing micronutrients and antioxidants), which have shown encouraging results in clinical studies in reducing floater-related symptoms and improving visual comfort, although longer-term data is still evolving.
When should you see an eye specialist?
You should arrange an eye examination if:
Floaters are new or suddenly increase
Are associated with flashing lights
Are associated with blurred vision
Are associated with pain or sensitivity to light
You are unsure whether they are normal
They are affecting your daily activities
A practical perspective
In clinic, one of the most common concerns I hear is:
“I’ve had floaters for years—should I be worried?”
In many cases, the answer is no. But the important distinction is:
⚠️ New or changing floaters should always be checked
Final thoughts
Floaters are a very common part of the ageing process of the eye. Most are harmless, but occasionally, they are the first sign of a retinal problem that requires urgent attention.
If you notice a sudden change in floaters or flashes of light
It’s worth having your eyes checked promptly to ensure your retina is healthy - even if your vision otherwise feels normal.
You may also be interested in:
Flashes of light in your vision: what it means